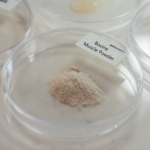
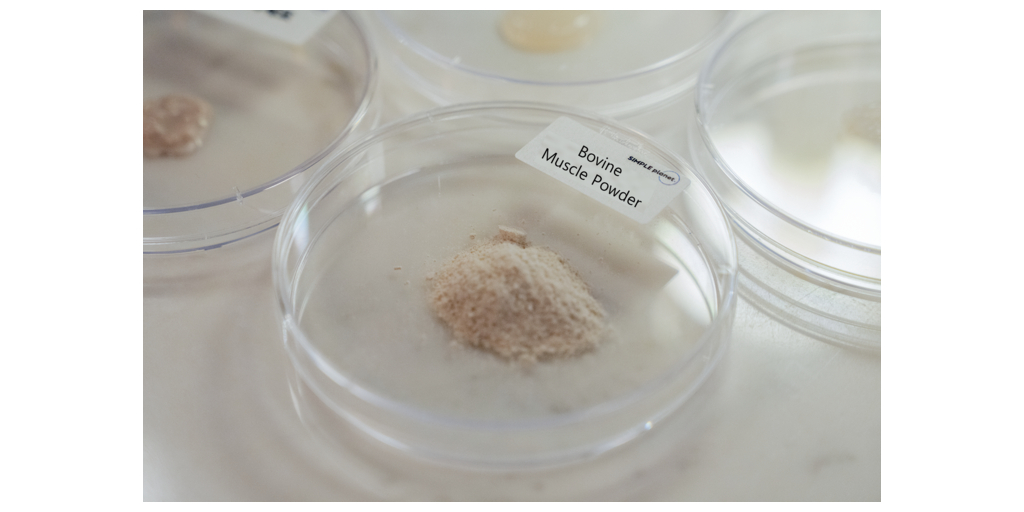

SEOUL, South Korea–(BUSINESS WIRE)–#FutureFoodIngredient—Simple Planet is a biotech food company that develops functional future food ingredients with a cell culture platform and cell organization technology. With a cell line development platform specialized in mass production, Simple Planet has established 13 different cell lines to date. It has developed a low-cost probiotics-based serum-free edible culture medium to replace the conventional FBS (fetal bovine serum), which currently accounts for over 80% of cell-based food production costs. This cost reduction along with plans to establish branches in the U.S. and Canada will enable faster entry towards the commercialization of cell-based food.
The increasing population and demands for conventional meat present challenges that the traditional food production system cannot cope with. According to the Food and Agriculture Organization, land used for the livestock industry accounts for 83% of the world’s agricultural land, and one-third of global grain production is processed as feed grains. Cellular agriculture is now emerging as a solution to overcome such resource constraints, thereby promoting biodiversity maintenance and resource circulation.
Simple Planet uniquely participates in this trend by isolating cells from livestock tissues and cultivating them in large quantities to produce cell-based ingredients such as alternative protein and unsaturated fats in a powdered or paste form, instead of the widely-developed hybrid cultivated meat form. These high-protein powders and customizable unsaturated fatty acids can be used as food ingredients with unlimited applications. They can enhance absorption and improve the flavor and the nutritional structure of any conventional food product, and can also be used as specialized functional ingredients targeting seniors and infants.
“Simple Planet’s cell-based food ingredients will be supplied diversely as target materials in the global cultivated meat market, and we are preparing for commercialization and global market entry starting with the establishment of our North American branches in the second half of 2023,” said Il Doo Jeong, CEO of Simple Planet.
Simple Planet’s technology and innovation have been acknowledged globally. It ranked on 2022 Food-tech 500 presented by Food Forwarding in the UK, which selects groundbreaking start-ups in the agri-food tech landscape, and they were the only Asia-based finalist selected in MassChallenge Switzerland 2023, an early-stage startup accelerator. Simple Planet signed an investment agreement with Pulmuone, a plant-based food manufacturing company in Korea, to accelerate its product commercialization.
Contacts
Simple Planet
JUHEE KIM +82-70-5097-5994
[email protected]